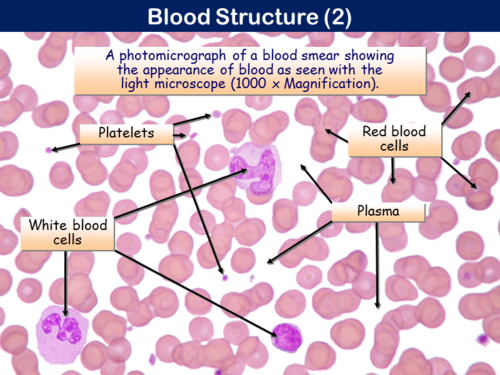
PNG, 686.51 KB
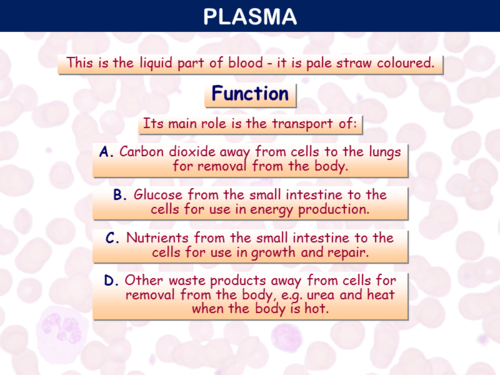
PNG, 261.56 KB
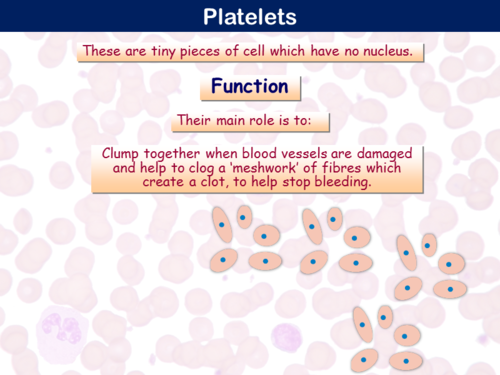
PNG, 319.95 KB

One of over 40 interactive and animated PowerPoint presentations (many with complementary workbooks) which together cover the core content of any PE/Sports Studies course in the 14 – 16+ age range. Already used in hundreds of UK and international schools.
• Works on all operating systems where MS PowerPoint has been installed, e.g. Windows, Mac OS, iOS and Android (this presentation is flash-free).
• Utilizes the benefits of the staged display of information.
• Suitable for a single computer, network, interactive whiteboard or digital projector.
• Editable in PowerPoint (.pptx file supplied).
• Saving you hours in the preparation of high quality lessons.
Currently, the TES store for Premium Resources only allows a PowerPoint preview to consist of one content slide plus the Cover Slide and End Slide. Therefore, we have included a full set of slide images (.png files) to allow you to appreciate the full content of this presentation - you do not need to retain these images after download - just keep the .pptx file.
Get this resource as part of a bundle and save up to 3%
A bundle is a package of resources grouped together to teach a particular topic, or a series of lessons, in one place.
Something went wrong, please try again later.
This resource hasn't been reviewed yet
To ensure quality for our reviews, only customers who have purchased this resource can review it
Report this resourceto let us know if it violates our terms and conditions.
Our customer service team will review your report and will be in touch.